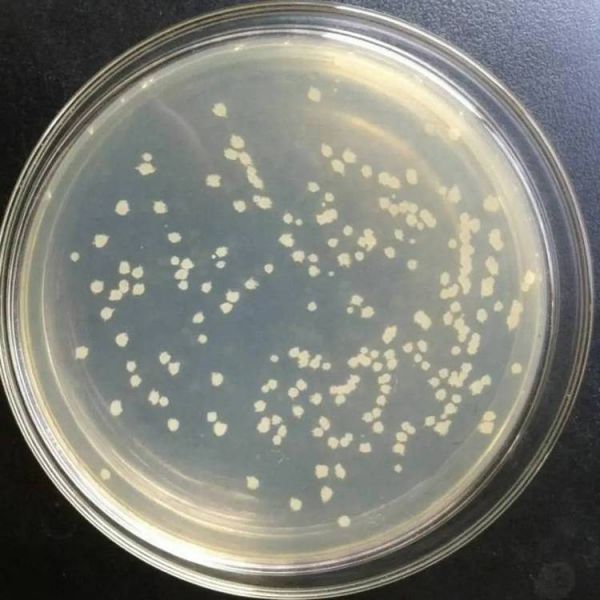

益昊生物高活菌解淀粉芽孢杆菌 防虫防病微生物菌剂提供
展开

解淀粉芽孢杆菌用于实验和科研检测用,属于菌株类,解淀粉芽孢杆菌对丁草胺具有明显的降解效果,解淀粉芽孢杆菌属革兰阳性芽孢杆菌,可污染医院75%酒精消毒液、潮湿损害的房屋、食品,造成新生儿、婴幼儿等的特殊人群感染和房屋污染健康综合征。






1、提高肥效、促磷的吸收
本品中含有的解淀粉芽孢杆菌为溶磷菌,具有繁殖快速、生命力强等特点,溶解土壤作物中不易吸收的钙磷、铁磷、铝磷等化合物,促进土壤中无效磷的溶解及利用。
2、提高作物产量、改善作物品质
本品中菌体生长产生大量蛋白酶、氨基酸、细胞分裂素等,增强农作物细胞活力,加快作物新陈代谢,增花增果,果实膨大快,口感好,大幅度提高作物的产量和农产品品级。
3、抗重茬、防病害
本品微生物能在植物根系周围快速定植并生长,其分泌大量高活性几丁质酶,快速清除致病菌,加快根瘤菌和根系的生长发育,促进作物根系发达,对作物因重茬和其它病害引起的根系小、根瘤少、植株矮小、枯黄、花叶、落叶、落花等生理病害有较强的预防效果。促进作物叶片变绿、变厚、植株健壮、扎根深、抗寒冻、抗旱、抗倒伏、抗早衰、抗重茬。

山东益昊生物科技有限公司是从事生物肥料相关的公司,位于山东潍坊,自2019年3月成立以来。本公司产品种类多样,主要有芽孢杆菌、乳酸菌、饲料添加剂、哈茨木霉菌等产品。山东益昊生物科技有限公司本着品质优先,顾客至上的理念,公道,品种多。山东益昊生物科技有限公司一直以质量求生存,以服务求发展,始终秉承重合同、守信用的理念,产品质优价美,欢迎广大新老客户前来选购!
供应商信息

山东益昊生物科技有限公司是一家以微生物为核心,专注于微生物制剂产品研究和生产的综合性生物企业,产品覆盖饲用生物制剂、农业微生物、食品益生菌和环保微生物四大领域。2014年成立以来,公司迅速发展壮大,截止目前,拥有4家子公司,员工100余人。企业技术中心拥有一支由3名博士和10余名硕士组成的高素质研发队伍,坚持自主研发的同时,积极与国内外院校、科研机构开展联合研发和技术合作,现拥有自主知识产权17余项。益昊生物拥有国际水平的科研设施和生产设备,目前拥有3台60m3生产罐,2台50m3生产罐,年产固体3000吨,液体2000吨,喷塔蒸发量3000Kg/小时,目前单体喷量。公司建立了完善的生产工艺和严密的质量管理体系,为稳定的产品质量保驾护航! 生物科技创造美好生活,益昊生物将始终秉承“开放、诚信、合作、共赢”的核心价值观,倡导“合作共赢、创值发展”的经营理念 ,以用户价值为导向,致力于成为全国用户信赖的微生态原料提供商,专业定制OEM/ODM代工。
查看更多 >
企业类型 其他有限责任公司 统一社会信用代码 91370725MA3P98PM58 成立日期 2019-03-08 法定代表人/负责人 赵尧尧 注册资本 500万(元) 注册地址 山东省潍坊市昌乐县开发区方山路1202号14幢 营业期限 2019-03-08 至 无固定期限 登记机关 昌乐县市场监督管理局 经营范围 许可项目:饲料添加剂生产;食品添加剂生产;饲料生产;食品销售;食品互联网销售;肥料生产。(依法须经批准的项目,经相关部门批准后方可开展经营活动,具体经营项目以相关部门批准文件或许可证件为准)一般项目:饲料原料销售;饲料添加剂销售;食品添加剂销售;食品销售(仅销售预包装食品);食品互联网销售(仅销售预包装食品);货物进出口;技术进出口;技术服务、技术开发、技术咨询、技术交流、技术转让、技术推广;肥料销售;复合微生物肥料研发;生物饲料研发;生物有机肥料研发。(除依法须经批准的项目外,凭营业执照依法自主开展经营活动)联系方式
相关知识
益昊生物高活菌解淀粉芽孢杆菌 防虫防病微生物菌剂提供
益昊生物高活性动宠物用微生物菌剂 防虫防病解淀粉芽孢杆菌供应
益昊生物高活性动宠物用冻干粉 防病害死苗巨大芽孢杆菌提供
益昊生物畜禽养殖用100亿丁酸梭菌 动宠物益生菌原料提供
解淀粉芽孢杆菌在动物生产中应用的研究进展
宠物营养补充剂——枯草芽孢杆菌
微生物水质调节、光合菌(59页)
宠物益生菌代加工源头厂家猫狗养护铁调节肠胃促消化复合菌剂
一种用于预防宠物腹泻的凝结芽孢杆菌King27及菌剂、制备方法和应用与流程
枯草芽孢杆菌对水质净化的重要作用
网址: 益昊生物高活菌解淀粉芽孢杆菌 防虫防病微生物菌剂提供 https://www.mcbbbk.com/newsview1342540.html
| 上一篇: 怎样防止孩子接触宠物身上的病菌和 |
下一篇: 弓形虫检查归来一切正常!其实做好 |
推荐分享
- 1养玉米蛇的危害 28694
- 2狗交配为什么会锁住?从狗狗生 7180
- 3我的狗老公李淑敏33——如何 6236
- 4豆柴犬为什么不建议养?可爱的 4637
- 5南京宠物粮食薄荷饼宠物食品包 4563
- 6中国境内禁养的十大鸟种,你知 4429
- 7湖南隆飞尔动物药业有限公司宠 4259
- 8自制狗狗辅食:棉花面纱犬的美 4257
- 9家养水獭多少钱一只正常 4212
- 10广州哪里卖宠物猫狗的选择性多 4122
